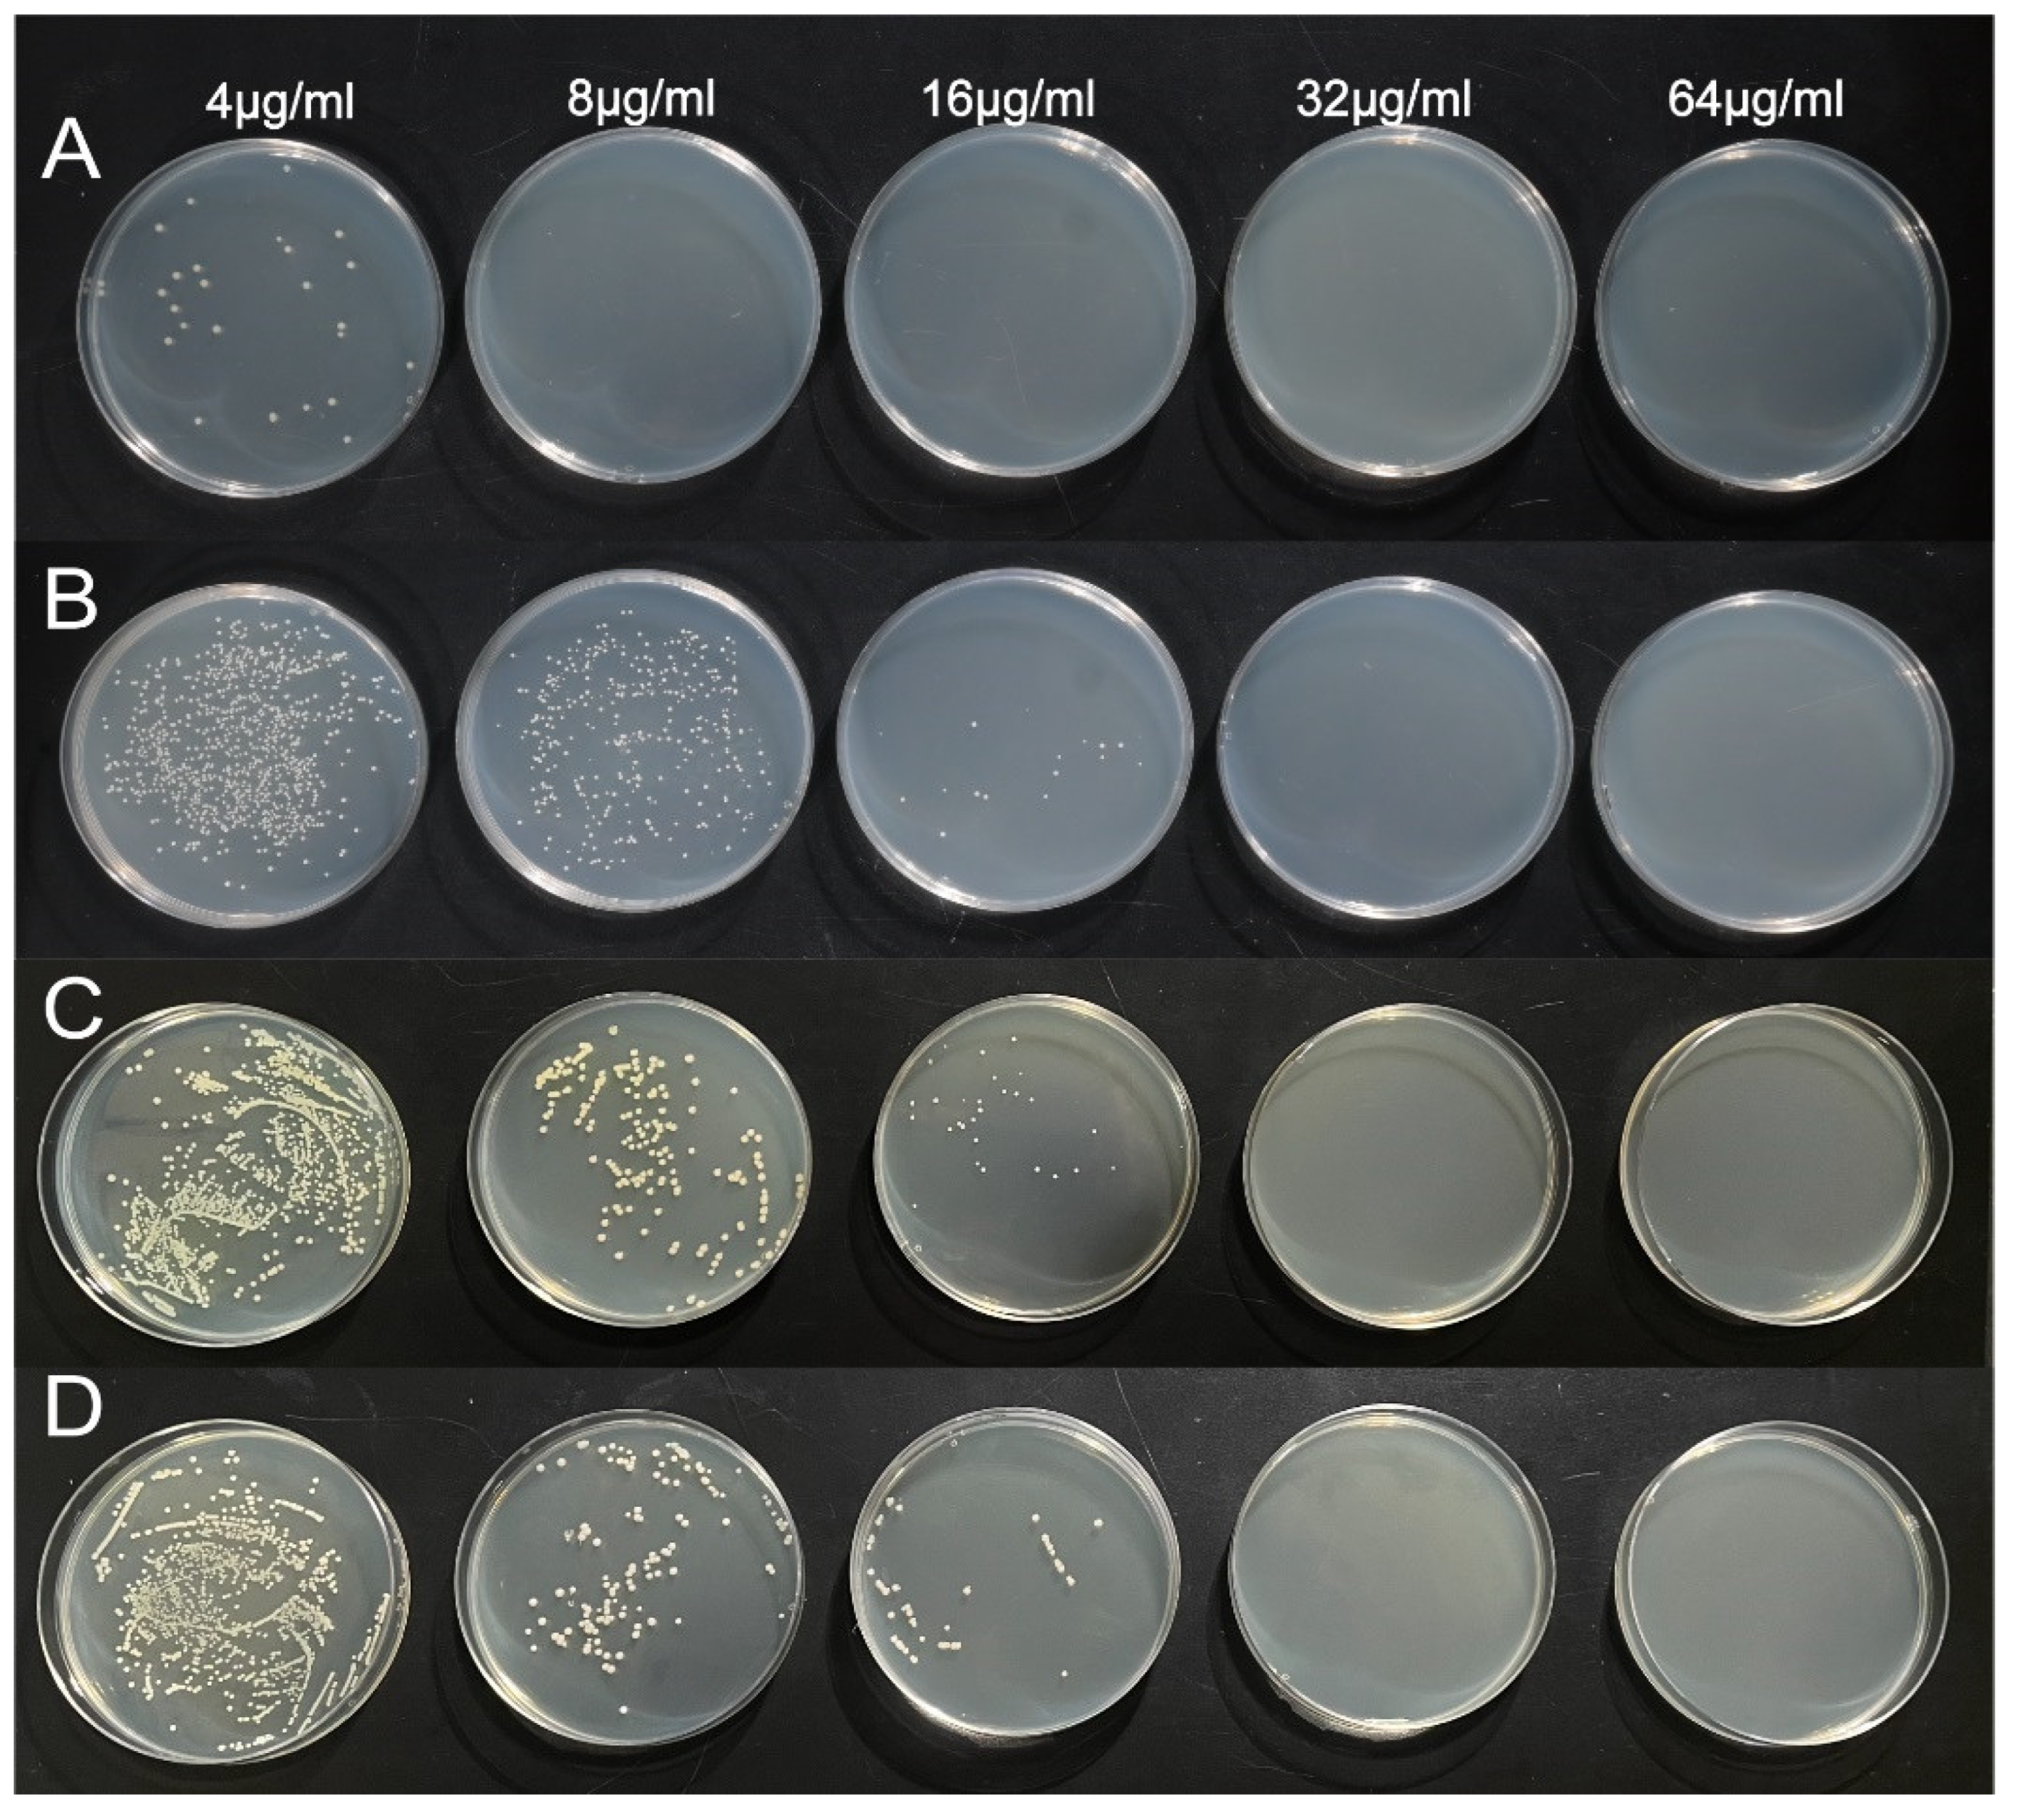
Ijms 25 01913 g007

Green Synthesis of Narrow-Size Silver Nanoparticles Using Ginkgo biloba Leaves: Condition Optimization, Characterization, and Antibacterial and Cytotoxic Activities
Abstract
1. Introduction
2. Results and Discussion
2.1. Characterization of Metabolites in the Leaf Extract by HPLC-MS Analysis
2.2. AgNP Synthesis
2.2.1. Effect of Silver Nitrate Concentration
2.2.2. Effect of the EGb Extract Concentration
2.2.3. Effect of the Reaction pH
2.2.4. Effect of the Reaction Temperature
2.2.5. Effect of the Reaction Time
2.3. Characterization of the Synthesized AgNPs
2.3.1. TEM Analysis
2.3.2. XRD Analysis
2.3.3. FTIR Analysis
2.4. Analysis of Potential Antimicrobial Activity
2.4.1. MBC and MIC Measurements
2.4.2. Growth Kinetics Assay
2.4.3. Agar Well Diffusion Assay
2.5. Cytotoxicity
3. Materials and Methods
3.1. Obtaining Ginkgo biloba Leaf Extract
3.2. High-performance Liquid Chromatography Coupled with Mass Spectrometry (HPLC-MS) Analysis
3.3. Synthesis of AgNPs
3.4. Characterization of Biosynthesized AgNPs
3.4.1. Ultraviolet–Visible Spectroscopy
3.4.2. Transmission Electron Microscopy (TEM)
3.4.3. X-ray Diffraction (XRD)
3.4.4. Fourier Transform Infrared Spectroscopy (FTIR)
3.5. Analysis of Potential Antimicrobial Activity
3.5.1. Bacterial Cell Culture
3.5.2. Determining the Minimum Inhibitory Concentration (MIC) and Minimum Bactericidal Concentration (MBC)
3.5.3. Growth Kinetics Assay
3.5.4. Agar Well Diffusion Assay
3.6. Cytotoxicity Assay
3.6.1. Cell Culture
3.6.2. Cytotoxicity Assays
3.7. Statistical Analyses
4. Conclusions
Author Contributions
Funding
Institutional Review Board Statement
Informed Consent Statement
Data Availability Statement
Conflicts of Interest
References
- Makabenta, J.M.V.; Nabawy, A.; Li, C.-H.; Schmidt-Malan, S.; Patel, R.; Rotello, V.M. Nanomaterial-based therapeutics for antibiotic-resistant bacterial infections. Nat. Rev. Microbiol. 2021, 19, 23–36. [Google Scholar] [CrossRef]
- Xie, M.; Gao, M.; Yun, Y.; Malmsten, M.; Rotello, V.M.; Zboril, R.; Akhavan, O.; Kraskouski, A.; Amalraj, J.; Cai, X.; et al. Antibacterial Nanomaterials: Mechanisms, Impacts on Antimicrobial Resistance and Design Principles. Angew. Chem. Int. Ed. 2023, 62, e202217345. [Google Scholar] [CrossRef] [PubMed]
- Doolan, J.A.; Williams, G.T.; Hilton, K.L.F.; Chaudhari, R.; Fossey, J.S.; Goult, B.T.; Hiscock, J.R. Advancements in antimicrobial nanoscale materials and self-assembling systems. Chem. Soc. Rev. 2022, 51, 8696–8755. [Google Scholar] [CrossRef] [PubMed]
- Della Pelle, F.; Scroccarello, A.; Sergi, M.; Mascini, M.; Del Carlo, M.; Compagnone, D. Simple and rapid silver nanoparticles based antioxidant capacity assays: Reactivity study for phenolic compounds. Food Chem. 2018, 256, 342–349. [Google Scholar] [CrossRef] [PubMed]
- Cieśla, J.; Chylińska, M.; Zdunek, A.; Szymańska-Chargot, M. Effect of different conditions of synthesis on properties of silver nanoparticles stabilized by nanocellulose from carrot pomace. Carbohydr. Polym. 2020, 245, 116513. [Google Scholar] [CrossRef]
- Shen, B. A New Golden Age of Natural Products Drug Discovery. Cell 2015, 163, 1297–1300. [Google Scholar] [CrossRef] [PubMed]
- Tyavambiza, C.; Meyer, M.; Wusu, A.D.; Madiehe, A.M.; Meyer, S. The Antioxidant and In Vitro Wound Healing Activity of Cotyledon orbiculata Aqueous Extract and the Synthesized Biogenic Silver Nanoparticles. Int. J. Mol. Sci. 2022, 23, 16094. [Google Scholar] [CrossRef] [PubMed]
- Shivakumar, M.; Nagashree, K.L.; Yallappa, S.; Manjappa, S.; Manjunath, K.S.; Dharmaprakash, M.S. Biosynthesis of silver nanoparticles using pre-hydrolysis liquor of Eucalyptus wood and its effective antimicrobial activity. Enzym. Microb. Technol. 2017, 97, 55–62. [Google Scholar] [CrossRef] [PubMed]
- Fahimirad, S.; Ajalloueian, F.; Ghorbanpour, M. Synthesis and therapeutic potential of silver nanomaterials derived from plant extracts. Ecotoxicol. Environ. Saf. 2019, 168, 260–278. [Google Scholar] [CrossRef]
- Jorge de Souza, T.A.; Rosa Souza, L.R.; Franchi, L.P. Silver nanoparticles: An integrated view of green synthesis methods, transformation in the environment, and toxicity. Ecotoxicol. Environ. Saf. 2019, 171, 691–700. [Google Scholar] [CrossRef]
- Alavi, M.; Karimi, N. Characterization, antibacterial, total antioxidant, scavenging, reducing power and ion chelating activities of green synthesized silver, copper and titanium dioxide nanoparticles using Artemisia haussknechtii leaf extract. Artif. Cells Nanomed. Biotechnol. 2018, 46, 2066–2081. [Google Scholar] [CrossRef]
- Porras, G.; Chassagne, F.; Lyles, J.T.; Marquez, L.; Dettweiler, M.; Salam, A.M.; Samarakoon, T.; Shabih, S.; Farrokhi, D.R.; Quave, C.L. Ethnobotany and the Role of Plant Natural Products in Antibiotic Drug Discovery. Chem. Rev. 2021, 121, 3495–3560. [Google Scholar] [CrossRef]
- Hembram, K.C.; Kumar, R.; Kandha, L.; Parhi, P.K.; Kundu, C.N.; Bindhani, B.K. Therapeutic prospective of plant-induced silver nanoparticles: Application as antimicrobial and anticancer agent. Artif. Cells Nanomed. Biotechnol. 2018, 46, S38–S51. [Google Scholar] [CrossRef]
- Wang, Z.; Zhang, J.; Ren, T.; Dong, Z. Targeted metabolomic profiling of cardioprotective effect of Ginkgo biloba L. extract on myocardial ischemia in rats. Phytomedicine 2016, 23, 621–631. [Google Scholar] [CrossRef]
- Ahmed, H.H.; El-Abhar, H.S.; Hassanin, E.A.K.; Abdelkader, N.F.; Shalaby, M.B. Ginkgo biloba L. leaf extract offers multiple mechanisms in bridling N-methylnitrosourea—Mediated experimental colorectal cancer. Biomed. Pharmacother. 2017, 95, 387–393. [Google Scholar] [CrossRef] [PubMed]
- Savaskan, E.; Mueller, H.; Hoerr, R.; von Gunten, A.; Gauthier, S. Treatment effects of Ginkgo biloba extract EGb 761® on the spectrum of behavioral and psychological symptoms of dementia: Meta-analysis of randomized controlled trials. Int. Psychogeriatr. 2018, 30, 285–293. [Google Scholar] [CrossRef] [PubMed]
- Mousavi, S.N.; Hosseinikia, M.; Yousefi Rad, E.; Saboori, S. Beneficial effects of Ginkgo biloba leaf extract on inflammatory markers: A systematic review and meta-analysis of the clinical trials. Phytother. Res. 2022, 36, 3459–3469. [Google Scholar] [CrossRef] [PubMed]
- Liu, X.-G.; Lu, X.; Gao, W.; Li, P.; Yang, H. Structure, synthesis, biosynthesis, and activity of the characteristic compounds from Ginkgo biloba L. Nat. Prod. Rep. 2021, 39, 474–511. [Google Scholar] [CrossRef] [PubMed]
- Ren, Y.-Y.; Yang, H.; Wang, T.; Wang, C. Green synthesis and antimicrobial activity of monodisperse silver nanoparticles synthesized using Ginkgo biloba leaf extract. Phys. Lett. A 2016, 380, 3773–3777. [Google Scholar] [CrossRef]
- Wang, F.; Zhang, W.; Tan, X.; Wang, Z.; Li, Y.; Li, W. Extract of Ginkgo biloba leaves mediated biosynthesis of catalytically active and recyclable silver nanoparticles. Colloids Surfaces A Physicochem. Eng. Asp. 2019, 563, 31–36. [Google Scholar] [CrossRef]
- Mashwani, Z.-U.-R.; Khan, M.A.; Khan, T.; Nadhman, A. Applications of plant terpenoids in the synthesis of colloidal silver nanoparticles. Adv. Colloid Interface Sci. 2016, 234, 132–141. [Google Scholar] [CrossRef]
- Sidorowicz, A.; Fais, G.; Casula, M.; Borselli, M.; Giannaccare, G.; Locci, A.M.; Lai, N.; Orrù, R.; Cao, G.; Concas, A. Nanoparticles from Microalgae and Their Biomedical Applications. Mar. Drugs 2023, 21, 352. [Google Scholar] [CrossRef]
- Jiang, X.; Zhang, J.; Lo, P.K.; Mao, Z. Polyphenol-Based Assembly Nanosystems as Multifunctional Biopharmaceutical Platform. Adv. NanoBiomed Res. 2023, 3, 2200168. [Google Scholar] [CrossRef]
- Khan, M.R.; Adam, V.; Rizvi, T.F.; Zhang, B.; Ahamad, F.; Jośko, I.; Zhu, Y.; Yang, M.; Mao, C. Nanoparticle–Plant Interactions: Two-Way Traffic. Small 2019, 15, e1901794. [Google Scholar] [CrossRef] [PubMed]
- Lin, G.; Rahim, A.; Leeming, M.G.; Cortez-Jugo, C.; Besford, Q.A.; Ju, Y.; Zhong, Q.-Z.; Johnston, S.T.; Zhou, J.; Caruso, F. Selective Metal–Phenolic Assembly from Complex Multicomponent Mixtures. ACS Appl. Mater. Interfaces 2019, 11, 17714–17721. [Google Scholar] [CrossRef]
- Ali, K.; Ahmed, B.; Dwivedi, S.; Saquib, Q.; Al-Khedhairy, A.A.; Musarrat, J. Microwave Accelerated Green Synthesis of Stable Silver Nanoparticles with Eucalyptus globulus Leaf Extract and Their Antibacterial and Antibiofilm Activity on Clinical Isolates. PLoS ONE 2015, 10, e0131178. [Google Scholar] [CrossRef] [PubMed]
- Bindhu, M.; Umadevi, M. Antibacterial and catalytic activities of green synthesized silver nanoparticles. Spectrochim. Acta Part A Mol. Biomol. Spectrosc. 2015, 135, 373–378. [Google Scholar] [CrossRef]
- Beg, M.; Maji, A.; Mandal, A.K.; Das, S.; Jha, P.K.; Hossain, M. Spectroscopic investigation on interaction of biogenic, Croton bonplandianum leaves extract mediated potential bactericidal silver nanoparticles with human hemoglobin and human serum albumin. J. Biomol. Struct. Dyn. 2018, 36, 711–723. [Google Scholar] [CrossRef]
- Hamedi, S.; Shojaosadati, S.A.; Shokrollahzadeh, S.; Hashemi-Najafabadi, S. Extracellular biosynthesis of silver nanoparticles using a novel and non-pathogenic fungus, Neurospora intermedia: Controlled synthesis and antibacterial activity. World J. Microbiol. Biotechnol. 2014, 30, 693–704. [Google Scholar] [CrossRef]
- Zaheer, Z. Biogenic synthesis, optical, catalytic, and in vitro antimicrobial potential of Ag-nanoparticles prepared using Palm date fruit extract. J. Photochem. Photobiol. B 2018, 178, 584–592. [Google Scholar] [CrossRef]
- Park, Y.; Noh, H.J.; Han, L.; Kim, H.-S.; Kim, Y.-J.; Choi, J.S.; Kim, C.-K.; Kim, Y.S.; Cho, S. Artemisia capillaris extracts as a green factory for the synthesis of silver nanoparticles with antibacterial activities. J. Nanosci. Nanotechnol. 2012, 12, 7087–7095. [Google Scholar] [CrossRef]
- Satpathy, S.; Patra, A.; Ahirwar, B.; Hussain, M.D. Antioxidant and anticancer activities of green synthesized silver nanoparticles using aqueous extract of tubers of Pueraria tuberosa. Artif. Cells Nanomed. Biotechnol. 2018, 46, 71–85. [Google Scholar] [CrossRef]
- Sathishkumar, M.; Sneha, K.; Yun, Y.-S. Immobilization of silver nanoparticles synthesized using Curcuma longa tuber powder and extract on cotton cloth for bactericidal activity. Bioresour. Technol. 2010, 101, 7958–7965. [Google Scholar] [CrossRef] [PubMed]
- Iravani, S.; Zolfaghari, B. Green synthesis of silver nanoparticles using Pinus eldarica bark extract. BioMed Res. Int. 2013, 2013, 639725. [Google Scholar] [CrossRef]
- Vivek, R.; Thangam, R.; Muthuchelian, K.; Gunasekaran, P.; Kaveri, K.; Kannan, S. Green biosynthesis of silver nanoparticles from Annona squamosa leaf extract and its in vitro cytotoxic effect on MCF-7 cells. Process. Biochem. 2012, 47, 2405–2410. [Google Scholar] [CrossRef]
- Alqadi, M.K.; Noqtah, O.A.A.; Alzoubi, F.Y.; Alzouby, J.; Aljarrah, K. pH effect on the aggregation of silver nanoparticles synthesized by chemical reduction. Mater. Sci.-Pol. 2014, 32, 107–111. [Google Scholar] [CrossRef]
- Nahar, K.; Rahaman, M.H.; Khan, G.M.; Islam, M.; Al-Reza, S. Green synthesis of silver nanoparticles from Citrus sinensis peel extract and its antibacterial potential. Asian J. Green Chem. 2020, 5, 135–150. [Google Scholar] [CrossRef]
- Mohanta, Y.K.; Panda, S.K.; Syed, A.; Ameen, F.; Bastia, A.K.; Mohanta, T.K. Bio-inspired synthesis of silver nanoparticles from leaf extracts of Cleistanthus collinus (Roxb.): Its potential antibacterial and anticancer activities. IET Nanobiotechnol. 2018, 12, 343–348. [Google Scholar] [CrossRef]
- Ji, J.; Zhao, L.; Liu, X.; Wu, H.; Wang, D.; Liu, D.; Chen, X.; Feng, S. Green synthesis, characterization of formononetin mediated AgNPs and its testing for formothion in typical fruit and vegetable samples. J. Food Compos. Anal. 2022, 112, 104572. [Google Scholar] [CrossRef]
- Tippayawat, P.; Phromviyo, N.; Boueroy, P.; Chompoosor, A. Green synthesis of silver nanoparticles in aloe vera plant extract prepared by a hydrothermal method and their synergistic antibacterial activity. PeerJ 2016, 4, e2589. [Google Scholar] [CrossRef]
- Singh, S.P.; Mishra, A.; Shyanti, R.K.; Singh, R.P.; Acharya, A. Silver Nanoparticles Synthesized Using Carica papaya Leaf Extract (AgNPs-PLE) Causes Cell Cycle Arrest and Apoptosis in Human Prostate (DU145) Cancer Cells. Biol. Trace Elem. Res. 2021, 199, 1316–1331. [Google Scholar] [CrossRef]
- Mittal, A.K.; Bhaumik, J.; Kumar, S.; Banerjee, U.C. Biosynthesis of silver nanoparticles: Elucidation of prospective mechanism and therapeutic potential. J. Colloid Interface Sci. 2014, 415, 39–47. [Google Scholar] [CrossRef]
- Srikar, S.K.; Giri, D.D.; Pal, D.B.; Mishra, P.K.; Upadhyay, S.N. Green Synthesis of Silver Nanoparticles: A Review. Green Sustain. Chem. 2016, 06, 34–56. [Google Scholar] [CrossRef]
- Sidorowicz, A.; Margarita, V.; Fais, G.; Pantaleo, A.; Manca, A.; Concas, A.; Rappelli, P.; Fiori, P.L.; Cao, G. Characterization of nanomaterials synthesized from Spirulina platensis extract and their potential antifungal activity. PLoS ONE 2022, 17, e0274753. [Google Scholar] [CrossRef] [PubMed]
- Alolga, R.N.; Osae, R.; Essilfie, G.; Saalia, F.K.; Akaba, S.; Chikari, F. Sonication, osmosonication and vacuum-assisted osmosonication pretreatment of Ghanaian garlic slices: Effect on physicochemical properties and quality characteristics. Food Chem. 2021, 343, 128535. [Google Scholar] [CrossRef]
- Boateng, I.D.; Yang, X.-M. Do non-thermal pretreatments followed by intermediate-wave infrared drying affect toxicity, allergenicity, bioactives, functional groups, and flavor components of Ginkgo biloba seed? A case study. Ind. Crops Prod. 2021, 165, 113421. [Google Scholar] [CrossRef]
- Kokila, T.; Ramesh, P.S.; Geetha, D. Biosynthesis of AgNPs using Carica papaya peel extract and evaluation of its antioxidant and antimicrobial activities. Ecotoxicol. Environ. Saf. 2016, 134, 467–473. [Google Scholar] [CrossRef] [PubMed]
- Li, F.; Boateng, I.D.; Chen, S.; Yang, X.-M.; Soetanto, D.A.; Liu, W. Pulsed light irradiation improves degradation of ginkgolic acids and retainment of ginkgo flavonoids and terpene trilactones in Ginkgo biloba leaves. Ind. Crops Prod. 2023, 204, 117297. [Google Scholar] [CrossRef]
- Jose, J.; Anas, A.; Jose, B.; Puthirath, A.B.; Athiyanathil, S.; Jasmin, C.; Anantharaman, M.R.; Nair, S.; Subrahmanyam, C.; Biju, V. Extinction of Antimicrobial Resistant Pathogens Using Silver Embedded Silica Nanoparticles and an Efflux Pump Blocker. ACS Appl. Bio Mater. 2019, 2, 4681–4686. [Google Scholar] [CrossRef]
- Agnihotri, S.; Mukherji, S.; Mukherji, S. Size-controlled silver nanoparticles synthesized over the range 5–100 nm using the same protocol and their antibacterial efficacy. RSC Adv. 2013, 4, 3974–3983. [Google Scholar] [CrossRef]
- Rodríguez-León, E.; Íñiguez-Palomares, R.A.; Navarro, R.E.; Rodríguez-Beas, C.; Larios-Rodríguez, E.; Alvarez-Cirerol, F.J.; Íñiguez-Palomares, C.; Ramírez-Saldaña, M.; Martínez, J.H.; Martínez-Higuera, A.; et al. Silver nanoparticles synthesized with Rumex hymenosepalus extracts: Effective broad-spectrum microbicidal agents and cytotoxicity study. Artif. Cells Nanomed. Biotechnol. 2018, 46, 1194–1206. [Google Scholar] [CrossRef]
- Tang, S.; Zheng, J. Antibacterial Activity of Silver Nanoparticles: Structural Effects. Adv. Healthc. Mater. 2018, 7, 1701503. [Google Scholar] [CrossRef] [PubMed]
- Moorthy, K.; Chang, K.-C.; Yu, P.-J.; Wu, W.-J.; Liao, M.-Y.; Huang, H.-C.; Chien, H.-C.; Chiang, C.-K. Synergistic actions of phytonutrient capped nanosilver as a novel broad-spectrum antimicrobial agent: Unveiling the antibacterial effectiveness and bactericidal mechanism. New J. Chem. 2022, 46, 15301–15312. [Google Scholar] [CrossRef]
- Kaiser, K.G.; Delattre, V.; Frost, V.J.; Buck, G.W.; Phu, J.V.; Fernandez, T.G.; Pavel, I.E. Nanosilver: An Old Antibacterial Agent with Great Promise in the Fight against Antibiotic Resistance. Antibiotics 2023, 12, 1264. [Google Scholar] [CrossRef] [PubMed]
- Bezza, F.A.; Tichapondwa, S.M.; Chirwa, E.M. Synthesis of biosurfactant stabilized silver nanoparticles, characterization and their potential application for bactericidal purposes. J. Hazard. Mater. 2020, 393, 122319. [Google Scholar] [CrossRef] [PubMed]
- Hamedi, S.; Shojaosadati, S.A.; Mohammadi, A. Evaluation of the catalytic, antibacterial and anti-biofilm activities of the Convolvulus arvensis extract functionalized silver nanoparticles. J. Photochem. Photobiol. B Biol. 2017, 167, 36–44. [Google Scholar] [CrossRef] [PubMed]
- Rizzello, L.; Pompa, P.P. Nanosilver-based antibacterial drugs and devices: Mechanisms, methodological drawbacks, and guidelines. Chem. Soc. Rev. 2014, 43, 1501–1518. [Google Scholar] [CrossRef] [PubMed]
- Devasvaran, K.; Alallam, B.; Yunus, M.A.; Dewi, F.R.P.; Kamal, N.N.S.N.M.; Lim, V. Microwave-assisted green synthesis of silver nanoparticles using alkaline extracted crude polysaccharide of C. nutans: Optimisation, characterisation, toxicity, anticancer potential and antibacterial studies. J. Drug Deliv. Sci. Technol. 2023, 86, 104688. [Google Scholar] [CrossRef]
- Jeeva, K.; Thiyagarajan, M.; Elangovan, V.; Geetha, N.; Venkatachalam, P. Caesalpinia coriaria leaf extracts mediated biosynthesis of metallic silver nanoparticles and their antibacterial activity against clinically isolated pathogens. Ind. Crops Prod. 2014, 52, 714–720. [Google Scholar] [CrossRef]
- Talank, N.; Morad, H.; Barabadi, H.; Mojab, F.; Amidi, S.; Kobarfard, F.; Mahjoub, M.A.; Jounaki, K.; Mohammadi, N.; Salehi, G.; et al. Bioengineering of green-synthesized silver nanoparticles: In vitro physicochemical, antibacterial, biofilm inhibitory, anticoagulant, and antioxidant performance. Talanta 2022, 243, 123374. [Google Scholar] [CrossRef]
- Adebayo-Tayo, B.; Salaam, A.; Ajibade, A. Green synthesis of silver nanoparticle using Oscillatoria sp. extract, its antibacterial, antibiofilm potential and cytotoxicity activity. Heliyon 2019, 5, e02502. [Google Scholar] [CrossRef]
- Huma, Z.; Javed, I.; Zhang, Z.; Bilal, H.; Sun, Y.; Hussain, S.Z.; Davis, T.P.; Otzen, D.E.; Landersdorfer, C.B.; Ding, F.; et al. Nanosilver Mitigates Biofilm Formation via FapC Amyloidosis Inhibition. Small 2020, 16, e1906674. [Google Scholar] [CrossRef]
- Gajera, G.; Thakkar, N.; Godse, C.; DeSouza, A.; Mehta, D.; Kothari, V. Sub-lethal concentration of a colloidal nanosilver formulation (Silversol®) triggers dysregulation of iron homeostasis and nitrogen metabolism in multidrug resistant Pseudomonas aeruginosa. BMC Microbiol. 2023, 23, 303. [Google Scholar] [CrossRef]
- Mazur, P.; Skiba-Kurek, I.; Mrowiec, P.; Karczewska, E.; Drożdż, R. Synergistic ROS-Associated Antimicrobial Activity of Silver Nanoparticles and Gentamicin against Staphylococcus epidermidis. Int. J. Nanomed. 2020, 15, 3551–3562. [Google Scholar] [CrossRef]
- Wan, G.; Ruan, L.; Yin, Y.; Yang, T.; Ge, M.; Cheng, X. Effects of silver nanoparticles in combination with antibiotics on the resistant bacteria Acinetobacter baumannii. Int. J. Nanomed. 2016, 11, 3789–3800. [Google Scholar] [CrossRef]
- Habash, M.B.; Park, A.J.; Vis, E.C.; Harris, R.J.; Khursigara, C.M. Synergy of silver nanoparticles and aztreonam against Pseudomonas aeruginosa PAO1 biofilms. Antimicrob. Agents Chemother. 2014, 58, 5818–5830. [Google Scholar] [CrossRef]
- Liao, C.; Li, Y.; Tjong, S.C. Bactericidal and Cytotoxic Properties of Silver Nanoparticles. Int. J. Mol. Sci. 2019, 20, 449. [Google Scholar] [CrossRef] [PubMed]
- Soares, T.; Ribeiro, D.; Proença, C.; Chisté, R.C.; Fernandes, E.; Freitas, M. Size-dependent cytotoxicity of silver nanoparticles in human neutrophils assessed by multiple analytical approaches. Life Sci. 2016, 145, 247–254. [Google Scholar] [CrossRef] [PubMed]
- Xu, Z.; Feng, Q.; Wang, M.; Zhao, H.; Lin, Y.; Zhou, S. Green Biosynthesized Silver Nanoparticles with Aqueous Extracts of Ginkgo biloba Induce Apoptosis via Mitochondrial Pathway in Cervical Cancer Cells. Front. Oncol. 2020, 10, 575415. [Google Scholar] [CrossRef] [PubMed]
- Jadhav, K.; Deore, S.; Dhamecha, D.; Rajeshwari, H.R.; Jagwani, S.; Jalalpure, S.; Bohara, R. Phytosynthesis of Silver Nanoparticles: Characterization, Biocompatibility Studies, and Anticancer Activity. ACS Biomater. Sci. Eng. 2018, 4, 892–899. [Google Scholar] [CrossRef] [PubMed]
- Akter, M.; Sikder, M.T.; Rahman, M.M.; Ullah, A.K.M.A.; Hossain, K.F.B.; Banik, S.; Hosokawa, T.; Saito, T.; Kurasaki, M. A systematic review on silver nanoparticles-induced cytotoxicity: Physicochemical properties and perspectives. J. Adv. Res. 2018, 9, 1–16. [Google Scholar] [CrossRef] [PubMed]
- Chowdhury, N.R.; MacGregor-Ramiasa, M.; Zilm, P.; Majewski, P.; Vasilev, K. ‘Chocolate’ silver nanoparticles: Synthesis, antibacterial activity and cytotoxicity. J. Colloid Interface Sci. 2016, 482, 151–158. [Google Scholar] [CrossRef] [PubMed]
- Ramachandran, R.; Krishnaraj, C.; Sivakumar, A.S.; Prasannakumar, P.; Kumar, V.A.; Shim, K.S.; Song, C.-G.; Yun, S.-I. Anticancer activity of biologically synthesized silver and gold nanoparticles on mouse myoblast cancer cells and their toxicity against embryonic zebrafish. Mater. Sci. Eng. C 2017, 73, 674–683. [Google Scholar] [CrossRef] [PubMed]
- Sanyasi, S.; Majhi, R.K.; Kumar, S.; Mishra, M.; Ghosh, A.; Suar, M.; Satyam, P.V.; Mohapatra, H.; Goswami, C.; Goswami, L. Polysaccharide-capped silver Nanoparticles inhibit biofilm formation and eliminate multi-drug-resistant bacteria by disrupting bacterial cytoskeleton with reduced cytotoxicity towards mammalian cells. Sci. Rep. 2016, 6, 24929. [Google Scholar] [CrossRef]
- Mohanta, Y.K.; Panda, S.K.; Biswas, K.; Tamang, A.; Bandyopadhyay, J.; De, D.; Mohanta, D.; Bastia, A.K. Biogenic synthesis of silver nanoparticles from Cassia fistula (Linn.): In Vitro assessment of their antioxidant, antimicrobial and cytotoxic activities. IET Nanobiotechnol. 2016, 10, 438–444. [Google Scholar] [CrossRef]

| Peak No. | RT (min) | m/z | Adduct/Charge | Main Fragments Ions | Compound Identification | Compound Class |
|---|---|---|---|---|---|---|
| 18 | 14.41 | 593.1478 | [M-H]− | 284,593 | Kaempferol-3-O-rutinoside isomer | Flavonoid |
| 27 | 19.94 | 577.2663 | [M-H]− | 225, 577 | Chrysin 7-gentiobioside | Flavonoid |
| 20 | 14.65 | 623.1584 | [M+FA-H]− | 316, 470, 621 | Isorhamnetin-3-O-rutinoside | Flavonoid |
| 3 | 0.57 | 191.0561 | [M-H]− | 59, 85, 127, 191 | Quinic acid | Phenolic acid |
| 11 | 12.71 | 609.1445 | [M-H]− | 300, 609 | Quercetin-3-O-rutinoside | Flavonoid |
| 22 | 15.45 | 739.184 | [M-H]− | 284, 593, 739 | Tetrahydroxyflavones rutinosyl-rutinoside | Flavonoid |
| 10 | 12.52 | 739.2055 | [M-H]− | 284, 575, 739 | Kaempferol 3-O-(2,6-di-O-alpha-L-rhamnopyranosyl)-beta-D-galactopyranoside | Flavonoid |
| 30 | 21.02 | 577.2661 | [M-H]− | 80, 299, 575 | Chrysin 7-gentiobioside | Flavonoid |
| 21 | 15.03 | 593.1476 | [M-H]− | 284, 413, 593 | Kaempferol-rhamnosyl-glucoside | Flavonoid |
| 12 | 12.94 | 769.2158 | [M-H]− | 314, 769 | Typhaneoside | Flavonoid |
| 1 | 0.53 | 377.0841 | [M+Cl]− | 113, 341 | Sucrose | Carbohydrates |
| 26 | 17.84 | 537.0804 | [M-H]− | 159, 375, 537 | Amentoflavone | Flavonoid |
| 24 | 15.96 | 739.1841 | [M-H]− | 284, 593 | Robinin | Flavonoid |
| 15 | 14.09 | 419.2265 | [M-H2O-H]− | 113 | Swertimarin | Terpenoid |
| 25 | 16.99 | 343.0812 | [M-H]− | 163, 313 | Eupatilin | Flavonoid |
| 16 | 14.23 | 447.091 | [M-H]− | 284, 447 | Kaempferol-3-O-glucoside | Flavonoid |
| 6 | 8.1 | 437.2364 | [M-H]− | 101, 391 | Blinin | Terpenoid |
| 8 | 12.19 | 463.0859 | [M-H]- | 151, 243, 303 | Quercetin-3-O-galactoside | Flavonoid |
| 9 | 12.47 | 463.086 | [M-H]− | 300, 445 | Quercetin-3-O-galactoside | Flavonoid |
| 17 | 14.25 | 609.1424 | [M-H]− | 300, 609 | Aureusidin 4,6-diglucoside | Flavonoid |
| 28 | 20.18 | 925.4212 | [M-H]− | 311, 925 | Kaikasaponin III | Saponin |
| 14 | 14.01 | 431.0958 | [M-H]− | 183, 255, 285 | Genistin | Flavonoid |
| 7 | 11.99 | 847.2623 | [2M-H]− | 423, 847 | Ginkgolide B | Terpenoid |
| 2 | 0.54 | 391.1033 | [M-H]− | 99, 217, 391 | Hyodeoxycholic acid | acid |
| 13 | 13.68 | 463.0851 | [M-H]− | 149, 301, 463 | Hyperin | Flavonoid |
| 5 | 7.18 | 439.1229 | [M-H]− | 97, 231, 365 | Ginkgolide C | Terpenoid |
| 29 | 20.94 | 293.2093 | [M-H]− | 79, 96, 167 | Tetradecylsulfate | Fatty acids |
| 19 | 14.54 | 477.1007 | [M-H]− | 314, 477 | MQ-O-glucoside 3 | Flavonoid |
| 23 | 15.45 | 369.0888 | [M-2H]2− | 145, 255 | Kaempferol 3-O-(2,6-di-O-alpha-L-rhamnopyranosyl)-beta-D-galactopyranoside | Flavonoid |
| 4 | 5.58 | 451.2161 | [M-H]− | 59, 179, 241, 403 | Calaliukiuenoside | Flavonoid |
| Sample No. | Parameter | Condition | Variable | UV (nm) |
|---|---|---|---|---|
| 1 | Concentration of AgNO3 (mM) | Plant extract: 10 mg/mL pH: 9 T: 40 °C Time: 30 min | 2 | 423 |
| 4 | 430 | |||
| 6 | 430 | |||
| 8 | 434 | |||
| 10 | 435 | |||
| 2 | Concentration of plant extract (mg/mL) | AgNO3: 6 mM pH: 9 T: 40 °C Time: 30 min | 2 | 420 |
| 4 | 426 | |||
| 6 | 440 | |||
| 8 | 430 | |||
| 10 | 430 | |||
| 3 | pH | AgNO3: 6 mM Plant extract: 10 mg/mL T: 40 °C Time:30 min | 3 | No |
| 5 | 420 | |||
| 7 | 433 | |||
| 9 | 433 | |||
| 11 | 405 | |||
| 4 | Temperature (°C) | AgNO3: 6 mM Plant extract: 10 mg/mL pH: 9 Time: 30 min | 27 | 413 |
| 40 | 433 | |||
| 60 | 430 | |||
| 80 | 396 | |||
| 90 | 396 | |||
| 5 | Time (min) | AgNO3: 6 mM Plant extract: 10 mg/mL pH: 9 T: 60 °C | 30 | 432 |
| 45 | 431 | |||
| 60 | 431 | |||
| 75 | 428 | |||
| 90 | 429 |
| Microorganisms | AgNPs (μg/mL) | MIC (μg/mL of Ag) | MBC (μg/mL of Ag) | |||||||
|---|---|---|---|---|---|---|---|---|---|---|
| 0.5 | 1 | 2 | 4 | 8 | 16 | 32 | 64 | |||
| E. coli | + | + | + | − | − | − | − | − | 4 | 8 |
| S. aureus | + | + | + | + | − | − | − | − | 8 | 32 |
| P. aeruginosa | + | + | + | + | − | − | − | − | 8 | 32 |
| A. baumanii | + | + | + | + | − | − | − | − | 8 | 32 |
| Zone Inhibition (mm) | |||||||
|---|---|---|---|---|---|---|---|
| AgNPs (μg/mL) | |||||||
| Sample | 4 | 8 | 16 | 32 | AgNO3 | Antibiotic | EGb |
| E. coli | 7.03 ± 0.46 | 8.08 ± 0.35 | 11.29 ± 2.83 | 12.62 ± 1.17 | 21.11 ± 0.75 | 18.17 ± 0.33 | NE |
| S. aureus | 7.40 ± 0.15 | 9.01 ± 0.50 | 11.90 ± 0.41 | 14.51 ± 0.57 | 28.64 ± 0.37 | 29.73 ± 0.67 | NE |
| P. aeruginosa | 9.29 ± 0.96 | 11.02 ± 1.54 | 13.36 ± 1.74 | 16.33 ± 2.08 | 27.17 ± 0.81 | 14.68 ± 1.33 | NE |
| A. baumanii | 7.85 ± 0.27 | 8.50 ± 0.17 | 10.64 ± 0.90 | 13.35 ± 1.37 | 23.60 ± 1.58 | 16.94 ± 0.96 | NE |
Disclaimer/Publisher’s Note: The statements, opinions and data contained in all publications are solely those of the individual author(s) and contributor(s) and not of MDPI and/or the editor(s). MDPI and/or the editor(s) disclaim responsibility for any injury to people or property resulting from any ideas, methods, instructions or products referred to in the content. |
© 2024 by the authors. Licensee MDPI, Basel, Switzerland. This article is an open access article distributed under the terms and conditions of the Creative Commons Attribution (CC BY) license (https://creativecommons.org/licenses/by/4.0/).
Share and Cite
Ni, Q.; Zhu, T.; Wang, W.; Guo, D.; Li, Y.; Chen, T.; Zhang, X. Green Synthesis of Narrow-Size Silver Nanoparticles Using Ginkgo biloba Leaves: Condition Optimization, Characterization, and Antibacterial and Cytotoxic Activities. Int. J. Mol. Sci. 2024, 25, 1913. https://doi.org/10.3390/ijms25031913
Ni Q, Zhu T, Wang W, Guo D, Li Y, Chen T, Zhang X. Green Synthesis of Narrow-Size Silver Nanoparticles Using Ginkgo biloba Leaves: Condition Optimization, Characterization, and Antibacterial and Cytotoxic Activities. International Journal of Molecular Sciences. 2024; 25(3):1913. https://doi.org/10.3390/ijms25031913
Chicago/Turabian StyleNi, Qi, Ting Zhu, Wenjie Wang, Dongdong Guo, Yixiao Li, Tianyu Chen, and Xiaojun Zhang. 2024. "Green Synthesis of Narrow-Size Silver Nanoparticles Using Ginkgo biloba Leaves: Condition Optimization, Characterization, and Antibacterial and Cytotoxic Activities" International Journal of Molecular Sciences 25, no. 3: 1913. https://doi.org/10.3390/ijms25031913
APA StyleNi, Q., Zhu, T., Wang, W., Guo, D., Li, Y., Chen, T., & Zhang, X. (2024). Green Synthesis of Narrow-Size Silver Nanoparticles Using Ginkgo biloba Leaves: Condition Optimization, Characterization, and Antibacterial and Cytotoxic Activities. International Journal of Molecular Sciences, 25(3), 1913. https://doi.org/10.3390/ijms25031913







